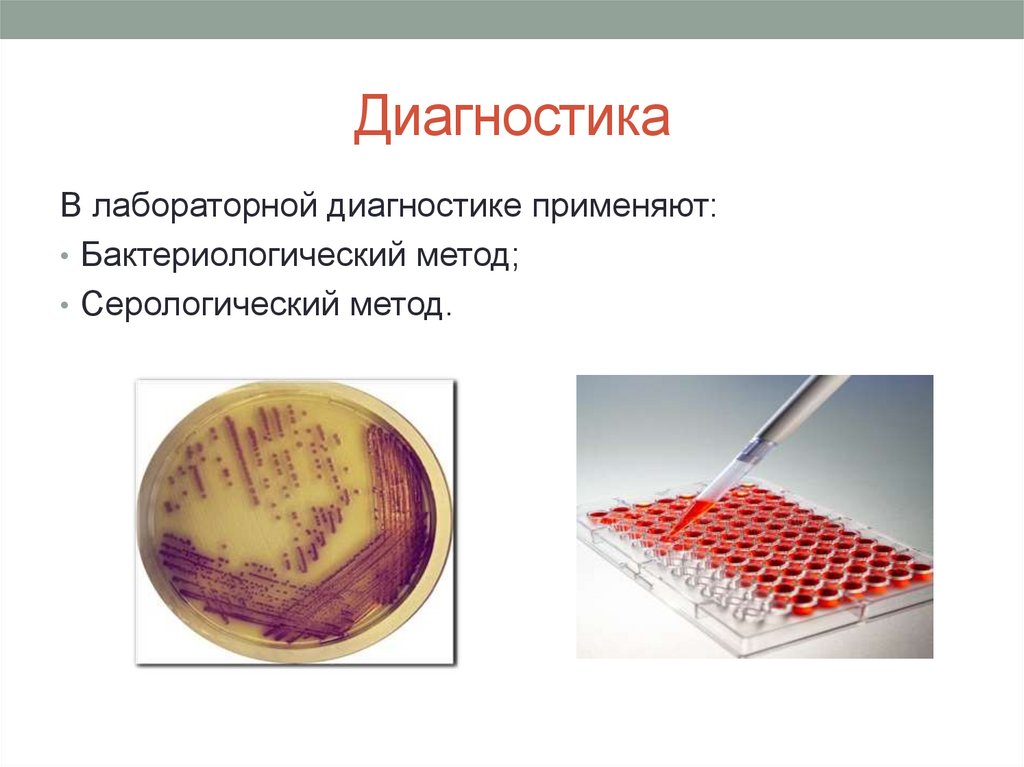

Similar presentations:
Лекция № 2. Брюшной тиф
1.
Государственное автономноепрофессиональное образовательное
учреждение «Казанский медицинский колледж»
ЛЕКЦИЯ № 2
Брюшной тиф
Преподаватель инфекционных
заболеваний Мансурова А.Н.
2.
Коды по МКБ-10• А01.0 Брюшной тиф
3.
Брюшной тифострая антропонозная инфекционная
болезнь с фекально-оральным
механизмом передачи,
характеризующаяся циклическим
течением, интоксикацией,
бактериемией и язвенным
поражением лимфатического
аппарата тонкой кишки.
4.
Этиология• Возбудитель
Salmonella
typhi,
принадлежит к роду Salmonella,
серологической группе D, семейству
кишечных бактерий Enterobacteriaceae.
• S. typhi имеет форму палочки с
закруглёнными концами, спор и капсул
не образует, подвижна имеет жгутики,
грамотрицательна, лучше растёт на
питательных
средах,
содержащих
жёлчь. При её разрушении происходит
освобождение эндотоксина.
• Антигенная
структура
S.
typhi
представлена О-, Н- и Vi-антигенами,
определяющими
выработку
соответствующих агглютининов.
5.
Этиология• S. typhi относительно хорошо сохраняется при низких
температурах, в воде и почве может сохраняться от
нескольких дней до нескольких месяцев.
Чувствительна к нагреванию: при 56 °С погибает в
течение 45–60 мин, при 60 °С — через 30 мин, при
кипячении — за несколько секунд. Благоприятная
среда для бактерий — пищевые продукты (молоко,
сметана, творог, мясной фарш, студень), в которых
они не только сохраняются, но и способны к
размножению.
6.
ЭПИДЕМИОЛОГИЯ• Источник: человек - больной или бактерионоситель.
Как источник инфекции больной наиболее опасен с 7го дня заболевания.
• Механизм передачи – фекально-оральный,
• Пути передачи инфекции - водный, пищевой,
контактно-бытовой.
• Восприимчивость – Индекс контагиозности
составляет 0,4. Наиболее часто заболевают люди в
возрасте от 15 до 40 лет.
• Сезонность – лето, осень.
• Иммунитет – продолжительный.
7.
Патогенез• Возбудитель попадает в организм через рот. Проникнув в
кишечник, возбудитель брюшного тифа внедряется в
лимфоидные образования тонкой кишки - одиночные и групповые
(пейеровы бляшки), солитарные фолликулы - и затем в
регионарные мезентериальные лимфатические узлы, что
приводит к развитию лимфаденита
• Из лимфатических образований возбудитель попадает в
кровеносное русло - начинается бактериемия, которая
соответствует первым клиническим проявлениям болезни.
Циркулирующие в крови микроорганизмы частично погибают,
высвобождается эндотоксин, обусловливающий
интоксикационный синдром, а при массивной эндотоксеми
развивается иинфекционно-токсический шок.
• Проникновение бактерий в паренхиматозные органы
(паренхиматозная диссеминация) сопровождается образованием
в них брюшнотифозных гранулем и нарушением их функций.
Одновременно с этим, начиная с 8-го дня болезни, происходит
массивное выделение возбудителя из организма с
испражнениями, а затем и мочой (выделительная фаза).
8.
Стадии патологического процесса:1.
2.
3.
4.
Мозговидное набухание групповых или солитарных
фолликулов-1-я неделя заболевания;
Некроз соллитарных фолликулов- 2-я неделя
Отторжение некротических масс и образование язв 3,4 недели заболевания
Стадия чистых язв - 5-6 –я неделя. Последнему
периоду
(5-6-я
неделя)
соответствует
фаза
формирования
специфического
иммунитета,
восстановления
гомеостаза
и
освобождения
организма от возбудителя, что характеризует
развитие ранней реконвалесценции
9.
Клиника• Инкубационный период: 7 — 21 дней(чаще 9—14
дней).
• Начальный период – 5-7 дней;
• Период разгара 1-2 недели;
• Период разрешения 1 неделя;
• Период реконвалесценции.
10.
Начальный период• Первая неделя болезни, характеризуется
преимущественно симптомами интоксикации:
наблюдается постепенно или остро (за 1-2 дня)
развившаяся гипертермия до 38-39 °С, выраженная
слабость, анорексия.
• Головная боль постоянного типа, бессонница ночью и
сонливость в дневные часы.
• У некоторых больных возникает диарея
тонкокишечного типа (стул типа «горохового супа»).
11.
Начальный период• Некоторая заторможенность и
адинамия.
• Умеренно выраженная бледность и
пастозностъ лица.
• Язык утолщен, с отпечатками зубов
на боковых поверхностях. Спинка
языка густо покрыта серовато-белым
налетом, края и кончик свободны от
налета, имеют насыщенно-красный
цвет.
• Зев умеренно гиперемирован. У
некоторых больных наблюдается
увеличение и гиперемия миндалин.
• Живот несколько вздут за счет
метеоризма. Отмечается
болезненность и урчание в
илеоцекальной области.
12.
Начальный период• К концу начального периода заболевания
наблюдается увеличение печени, реже - селезенки.
• В периферической крови в первые 3 дня болезни
отмечается лейкоцитоз со сдвигом лейкоцитарной
формулы влево, повышение СОЭ. С 4-5-го дня
болезни развивается лейкопения, анэозинофилия,
тромбоцитопения, относительный лимфоцитоз,
сохраняется повышение СОЭ.
• В урограмме: протеинурия, микрогематурия,
цилиндрурия
13.
Период разгара• В этот период усиливается интоксикация, и
температура тела больных достигает
максимально высокого уровня.
• Симптом относительной брадикардии (пульс
отстает от температуры).
• Гипотония, глухость сердечных тонов.
• Больные заторможены, негативны к
окружающему. При тяжелом течении болезни
может развиться status typhosus - резкая
слабость, апатия, адинамия, нарушение
сознания, бред, галлюцинации.
• На 8 -10-й день болезни у 55 - 65% больных
возникает экзантема. Чаще локализуется на
коже живота и нижней части груди. Это
мелкие розовые пятнышки (розеолы) каждый
элемент существует 1-5 дней. Могут
образовываться новые розеолы (феномен
«подсыпания»).
14.
Период разрешения• Начинается после нормализации температуры тела и
продолжается 2-3 недели. Уменьшается головная
боль, улучшается аппетит, увеличивается диурез.
Длительно сохраняется слабость(2-4 недели),
повышенная раздражительность, лабильность
психики, исхудание (2-4недели).
15.
Период реконвалесценции• Постепенная нормализация всех функций организма.
• Однако у части больных могут наступить обострение и
рецидив болезни.
• Обострения наступают во время спада болезни, но
еще до нормализации температуры тела; это новая
вспышка процесса.
• Рецидивы, или возвраты, болезни в отличие от
обострений наступают уже при нормальной
температуре тела и прекратившейся интоксикации.
16.
Осложнения• Специфические: кишечное кровотечение,
перфорация кишечных язв, инфекционно-токсический
шок.
• Неспецифические: пневмония, паротиты, отиты,
пиелиты, стоматиты и др.
17.
Осложнения• Кишечное кровотечение: чаще развиваются в
конце 3-й или 4-й недели, т.е. в сроки «чистых» язв.
Возникает внезапно, характеризуется следующими
симптомами:
• наличие в испражнениях примеси крови как черного
цвета (мелена), так и алой крови;
• бледность кожи;
• падение артериального давления;
• учащение пульса;
• резкое снижение температуры тела.
18.
ОсложненияПерфорация кишечных язв
Симптомы:
• Внезапная боль в животе «кинжальная»
• Мышечное напряжение брюшного пресса
«доскообразный» живот
• Пульс становится малым и частым, лицо
бледнеет, появляется холодный пот,
учащается дыхание, снижается
температура тела.
• Через несколько часов развивается
перитонит, интоксикация и лихорадка
нарастают, заостряются черты лица,
появляются рвота, исчезает печеночная
тупость, нет стула, не отходят газы,
появляются симптомы раздражения
брюшины (Щеткина-Блюмберга).
19.
Осложнения• ИТШ – синдром острой
недостаточности
кровообращения и
связанных с ней тяжелых
метаболических расстройств
в организме.
Симптомы:
• падает АД,
• появляется тахикардия,
• акроцианоз,
• одышка,
• снижается диурез вплоть до
анурии.
20.
ДиагностикаДиагноз основывается на клинической картине
заболевания, эпидемиологических данных,
лабораторных исследованиях.
21.
ДиагностикаВ лабораторной диагностике применяют:
• Бактериологический метод;
• Серологический метод.
22.
Диагностика• 1.Бактериологичкский метод (посев на 50-100 мл
желчного бульона или среду Раппоппорт( в
соотношении 1:10) при высокой температуре),
• а) на 1-2 недели – кровь на гемокультуру;
• б) на 2-3 недели – испражнения и моча, желчь.
23.
Диагностика• 2. Серологическое исследование сыворотки крови
– направлен на обнаружение антител (с 6 дня
болезни).
• ИФА, РА, РНГА диагностический титр - 1:200 и выше.
• Для выявления лиц с бессимптомным течением
заболевания назначают РНГА с Vi-антигеном.
24.
Лечение• Обязательная госпитализация.
• Режим – строгий постельный (весь период
лихорадки + неделя с момента нормализации
температуры). Затем постельный – 7 дней,
затем палатный.
• Диета – стол № 4а, при выздоровлении №15,
все периоды щадящая (ЩД). Больных кормить
4-5 раз в сутки.
• Для питья давать чай, настой шиповника,
щелочные минеральные воды, соки.
25.
ЛечениеЭтиотропная терапия :
• Антибиотики – (ципрофлоксацин по 0,5–0,75 г два раза в
день после еды; офлоксацин по 0,2–0,4 г два раза в день
внутрь или в/в; пефлоксацин по 0,4 г два раза в день
внутрь или в/в; цефтриаксон -1,0-2 в/в 1 раз в сутки) до 10го дня нормальной температуры.
Патогенетическая терапия :
• Дезинтоксикационная (Рингера, 5% раствор глюкозы,
реополиглюкин, и др.,
• Кортикостероидная терапия (переднизолон),в тяжелых
случаях.
• Антигистаминные препараты: супрастин, тавегил и др. • Витаминотерапия (Аскорбиновая кислота — в течение 20–
30 дней по 0,05 г три раза в день, витамин Е по 1 капсуле
(0,2 мл) 3 раза в день)
26.
ЛечениеСимптоматическая терапия :
• При необходимости назначают сердечно-сосудистые
препараты.
• При кишечном кровотечении - кровоостанавливающие
10% раствор хлорида натрия, аминокапроновую
кислоту, викасол 1%,1 мл.
• При перфорации кишечника – срочное хирургическое
вмешательство.
27.
ПРОФИЛАКТИКАСпецифическая:
• контактным лицам – бактериофаг;
• по эпидемическим показаниям (на территориях с высоким
уровнем заболевания брюшным тифом, лицам
относящимся к группам риска (работники очистных
сооружений, сотрудники инфекционных больниц), лицам
выезжающим в страны с высоким уровнем заболеваемости
брюшным тифом.
• Тифивак в дозе 0,5 мл подкожно, вторая прививка через 1
мес в дозе 1 мл, ревакцинация через 2 года в дозе 1 мл.
• С 3-летнего возраста применяют вакцину брюшнотифозную
Vi-полисахаридную жидкую (вианвак) в дозе 0,5 мл
подкожно однократно. Ревакцинация в той же дозе через 3
года.
28.
ПРОФИЛАКТИКА• Неспецифическая:
• Выписка из стационара после 3-х кратного отрицательного
результата исследования кала и мочи и 1 кратного
исследования желчи.
• Диспансерное наблюдение после выписки по месту
жительства в течении 2- х лет.
• Изоляция больных (госпитализация).
• Карантин контактировавшим 25 дней.
• Обследование на брюшной тиф всех групп, работающих
на пищевых производствах.
• Профилактическая и очаговая дезинфекци.
• Санитарный надзор за водоснабжением, пищевыми
производствами, общественным питанием, канализацией.
• Санитарно-просветительская работа с населением
29.
Противлэпидемические мероприятия вочаге
• -Обязательно отсылать экстренное извещение (ф. №
58) в ЦГСЭН.!!!!!!
• После госпитализации пациента проводится
заключительная дезинфекция.
• Контактных лиц наблюдают 25 дней с обязательным 1кратным бактериологическим исследованием кала.
• Декретированных лиц отстраняют от работы до
получения отрицательного результата исследования
кала.

medicine
medicine








